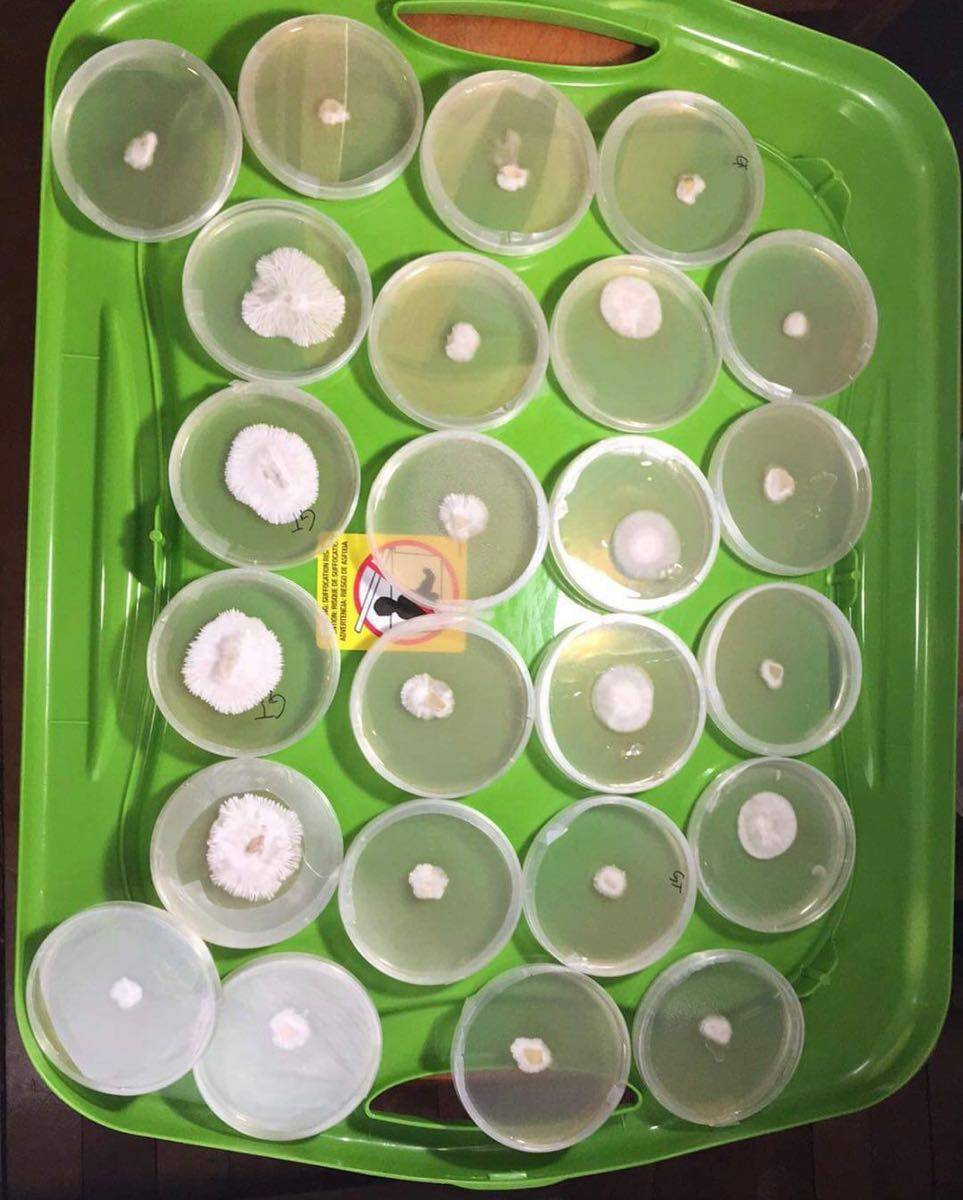
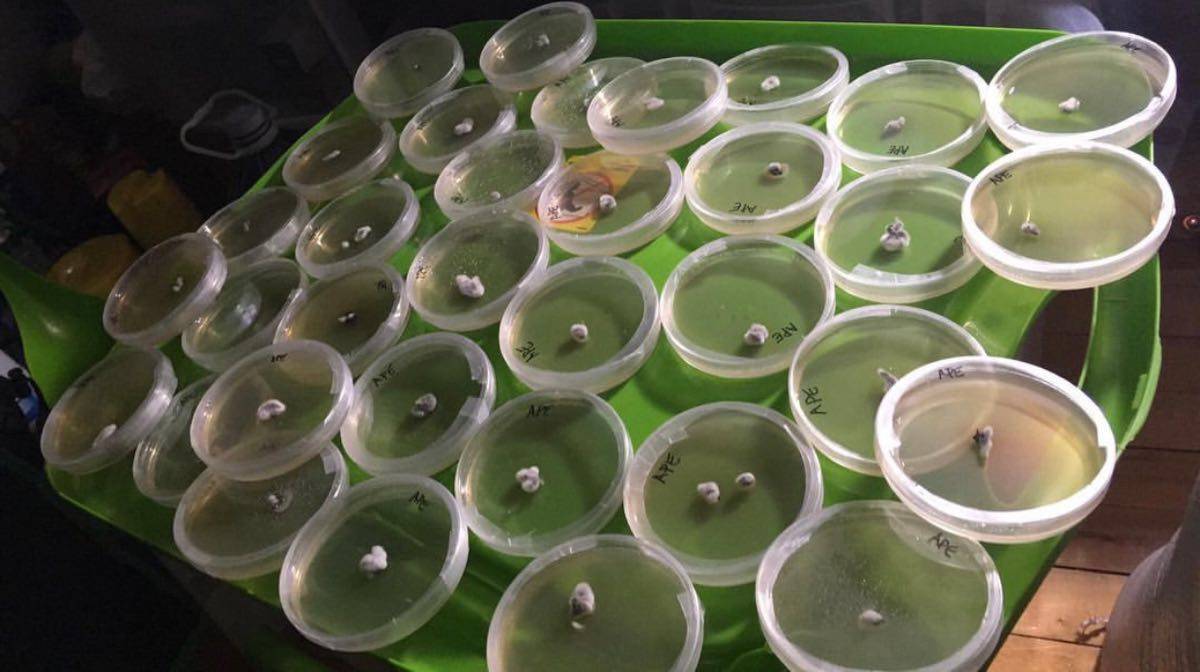

Agar is used in the cultivation of mushrooms in order to store cultures for long-term use and create mono-cultures free from contamination. … Agar plates are also used for making fungal clones. A clean fragment of the mushroom fruiting body can be placed on agar to grow rather than germinating spores.
Related products
-
๐๐ฟ๐ผ๐ ๐ง๐๐ฏ๐ฒ ๐๐ถ๐
$55.00Add to cartThere are many methods and approaches to growing mushrooms, but our go-to solution for cultivars at any level of experience will always be tubs. Why? Because they are easy, perfect for any environment, and provide multiple levels of protection. Whether youโre a DIYer first starting out to a professional grower, tubs will always be an …
-
๐๐๐ (๐๐๐๐ข ๐๐ข๐ง๐๐๐ฎ๐๐ค)
$300.00Original price was: $300.00.$250.00Current price is: $250.00.Add to cartJedi Mind Fuck are back by popular demand! They appear to be leucistic/albino โstrainsโ. And mutants like the PE varieties. FLAVOURS Sweet, Earthy and Fruity God Bud, Shishkaberry and Blueberry EFFECTS This product may make you feel Relaxed, Focused, Uplifted, Euphoric and Happy. MEDICAL EFFECTS This strain is great for Stress, Migraine Headaches, Depression, Fatigue, …
๐๐๐ (๐๐๐๐ข ๐๐ข๐ง๐๐๐ฎ๐๐ค)Read More
-
Best offers
Join Risk Free
7 days refund
100% Safe
Secure Shopping
24x7 Support
Online 24 hours
Flexible Payment
Pay with Multiple Payments
Free Shiping
On all order over 200+

Reviews
There are no reviews yet.